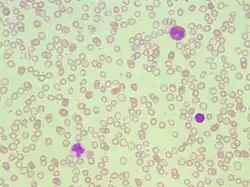

Beta thalassemia
| Beta-thalassemia | |
|---|---|
| Other names | Cooley's anemia, Mediterranean anemia[1] |
![]() | |
| Beta-thalassemia genetics, the picture shows one example of how beta-thalassemia is inherited. The beta-globin gene is located on chromosome 11. A child inherits two beta globin genes (one from each parent). | |
| Specialty | Hematology |
| Symptoms | Anemia, enlarged spleen, abnormal bone structure[1] |
| Usual onset | Between 6 and 24 months of age[1] |
| Types | Beta-thalassemia minor, intermedia and major[2] |
| Causes | Mutations in the HBB gene[3] |
| Risk factors | Family history, ancestry from the Mediterranean, West Africa, the Middle East, the Indian subcontinent or Southeast Asia[4][5] |
| Diagnostic method | Blood smear, hemoglobin electrophoresis, iron & ferritin tests, DNA analysis[6] |
| Differential diagnosis | Alpha thalassemia, sickle cell disease, iron deficiency anemia |
| Prevention | Preconception genetic counseling |
| Treatment | Blood transfusion, iron chelation, stem cell transplant, gene therapy |
Beta-thalassemia (β-thalassemia) is an inherited blood disorder, a form of thalassemia resulting in variable outcomes ranging from clinically asymptomatic to severe anemia individuals. It is caused by reduced or absent synthesis of the beta chains of hemoglobin, the molecule that carries oxygen in the blood.[7] Symptoms depend on the extent to which hemoglobin is deficient, and include anemia, pallor, tiredness, enlargement of the spleen, jaundice, and gallstones. In severe cases death ensues.[8]
Beta thalassemia occurs due to a mutation of the HBB gene leading to deficient production of the hemoglobin subunit beta-globin; the severity of the disease depends on the nature of the mutation, and whether or not the mutation is homozygous.[9][10] The body's inability to construct beta-globin leads to reduced or zero production of adult hemoglobin thus causing anemia.[11] The other component of hemoglobin, alpha-globin, accumulates in excess leading to ineffective production of red blood cells, increased hemolysis, and iron overload.[12] Diagnosis is by checking the medical history of near relatives, microscopic examination of blood smear, ferritin test, hemoglobin electrophoresis, and DNA sequencing.[13]
As an inherited condition, beta thalassemia cannot be prevented although genetic counselling of potential parents prior to conception can propose the use of donor sperm or eggs.[14] Patients may require repeated blood transfusions throughout life to maintain sufficient hemoglobin levels; this in turn may lead to severe problems associated with iron overload.[1] Medication includes folate supplementation, iron chelation, bisphosphonates, and removal of the spleen.[15] Beta thalassemia can also be treated by bone marrow transplant from a well matched donor,[16] or by gene therapy.[17]
Thalassemias were first identified in severely sick children in 1925,[18] with identification of alpha and beta subtypes in 1965.[19] Beta-thalassemia tends to be most common in populations originating from the Mediterranean, the Middle East, Central and Southeast Asia, the Indian subcontinent, and parts of Africa. This coincides with the historic distribution of Plasmodium falciparum malaria, and it is likely that a hereditary carrier of a gene for beta-thalassemia has some protection from severe malaria. However, because of population migration, β-thalassemia can be found around the world.[13] In 2005, it was estimated that 1.5% of the world's population are carriers and 60,000 affected infants are born with the thalassemia major annually.[20]
Signs and symptoms


Symptoms depend on the type and severity of thalassemia. Carriers of thalassemia genes may have no symptoms (thalassemia minor) or very mild symptoms with occasional crisis (thalassemia intermedia); individuals who are homozygous for the mutation have severe and life threatening symptoms (thalassemia major).[21][22]
Individuals with beta-thalassemia major usually present within the first two years of life with symptomatic severe anemia, poor growth, and skeletal abnormalities. Untreated thalassemia major eventually leads to death, usually by heart failure.[23]
Those with beta-thalassemia intermedia (those who are compound heterozygotes for the beta thalassemia mutation) usually present later in life with mild to moderate symptoms of anemia.[22]
Beta thalassemia trait (beta thalassemia minor) involves heterozygous inheritance of a beta-thalassemia mutation. Individuals usually have microcytosis with mild anemia; they are usually asymptomatic or have mild symptoms.[22] Beta thalassemia minor can also present as beta-thalassemia silent carriers; those who inherit a beta thalassemic mutation but have no hematologic abnormalities or symptoms.[22]
Individuals with thalassemia thalassemia major and intermedia (to a lesser extent) are susceptible to health complications that involve the spleen (hypersplenism) and gallstones (due to hyperbilirubinemia from peripheral hemolysis).[22][3] Additional symptoms of beta-thalassemia major or intermedia include the classic symptoms of anemia including fatigue, developmental delay in childhood, leg ulcers, and organ failure.[22] Ineffective erythropoiesis (red blood cell production) can lead to expansion of the bone marrow in compensation; this can then lead to deformity, bone pain, and craniofacial abnormalities.[22] Organs such as the liver and spleen that can also become enrolled in red blood cell production, leading to hepatosplenomegaly (enlargement of the liver and spleen).[22]
People with thalassemia can get too much iron in their bodies, either from the disease itself as RBCs are destroyed, or as a consequence of frequent blood transfusions. Excess iron is not excreted, but forms toxic non-transferrin-bound iron.[21][24] This can lead to organ damage, potentially affecting the heart, liver, endocrine system, bones and spleen. Symptoms include an irregular heartbeat, cardiomyopathy, cirrhosis of the liver, hypothyroidism, delayed puberty and fertility problems, brittle and deformed bones, and an enlarged spleen.[25][26]
For clinical purposes, thalassemia is categorised as either transfusion-dependent thalassemia (TDT) or non-transfusion-dependent thalassemia (NTDT) are used. Patients are usually considered as having NTDT if they have received fewer than 6 red blood cell units in the past 6 months and none in the preceding 2 months.[27]
Cause

Hemoglobin structural biology

Normal human hemoglobins are tetrameric proteins composed of two pairs of globin chains, each of which contains one alpha-like (α-like) chain and one beta-like (β-like) chain. Each globin chain is associated with an iron-containing heme molecular component. Throughout life, the synthesis of the alpha-like and the beta-like chains is balanced so that their ratio is relatively constant and there is no excess of either type.[28]
The specific alpha and beta-like chains that are incorporated into hemoglobins are highly regulated during development:[29]
- Embryonic hemoglobins are expressed as early as four to six weeks of embryogenesis and disappear around the eighth week of gestation as they are replaced by fetal hemoglobin.[30][31]
- Fetal hemoglobin (HbF) is produced from approximately eight weeks of gestation through to birth and constitutes approximately 80 percent of hemoglobin in the full-term neonate. It declines during the first few months of life and constitutes <1 percent of total hemoglobin by and past early childhood. HbF is composed of two alpha globins and two gamma globins (α2γ2).[29]
- Adult hemoglobin (HbA) is produced at low levels through embryonic and fetal life and is the predominant hemoglobin in children by six months of age and onward; it constitutes 96-97% of total hemoglobin in individuals without a hemoglobinopathy. It is composed of two alpha globins and two beta globins (α2β2).[29]
- Hemoglobin A2 (HbA2) is a minor adult hemoglobin that normally accounts for approximately 2.5-3.5% of total hemoglobin. It is composed of two alpha globins and two delta globins (α2δ2).[29]
Mutations
β-globin chains are encoded by the HBB gene on chromosome 11;[32] in a healthy person with two copies on each chromosome, two loci encode the β chain.[33] In beta thalassemia, a single faulty gene can be either asymptomatic or cause mild disease; if both genes are faulty this causes moderate to severe disease.[34]
More than 350 mutations have been identified which can cause beta thalassemia; 20 of these account for 80% of beta-thalassemia cases.[20]
Two major groups of mutations can be distinguished:
- Nondeletion forms: These defects, in general, involve a single base-pair substitution or small insertions near or upstream of the HBB gene.[35]
- Deletion forms: base-pair deletions of different sizes involving the HBB gene produce syndromes such as hereditary persistence of fetal hemoglobin syndrome.[36]
Mutations are characterized as (βo) if they prevent any formation of β globin chains, and mutations are characterized as (β+) if they allow some β globin chain formation to occur.[22]
| Name | Older synonyms | Description | Alleles |
|---|---|---|---|
| Thalassemia minor | Heterozygous form: Only one of the β globin alleles bears a mutation. Affected individuals will develop microcytic anemia. Detection usually involves a lower than normal mean corpuscular volume value (<80 fL).[37] | β+/β βo/β | |
| Thalassemia intermedia | Affected individuals can often manage a normal life but may need occasional transfusions, e.g., at times of illness or pregnancy, depending on the severity of their anemia.[38] | β+/β+ βo/β+ | |
| Thalassemia major | Mediterranean anemia; Cooley anemia | Homozygous form: Occurs when both alleles have thalassemia mutations. Untreated, it causes severe anemia, splenomegaly and bone deformities, and progresses to death before age 20. Treatment consists of periodic blood transfusion; splenectomy for splenomegaly and chelation of transfusion-related iron overload.[39] | βo/βo |
Due to globin defects, beta thalassemia patients do not have normal levels of adult hemoglobin (HbA), and instead have elevated levels of HbA2 (α2δ2).[10] Production of this form of hemoglobin may increase as a consequence of stress erythropoiesis.[40][10]
Diagnosis
Prenatal and newborn screening
Checking for hemoglobinopathies begins during pregnancy, with a prenatal screening questionnaire which includes, among other things, a consideration of health issues in the child's parents and close relatives. During pregnancy, genetic testing can be done on samples taken of fetal blood, of amniotic fluid, or chorionic villus sampling.[41][42] A routine heel prick test, in which a small sample of blood is collected a few days after birth, can detect some forms of hemoglobinopathy.[43]
Diagnostic tests
The initial tests for thalassemias are:
- Complete blood count (CBC): Checks the number, size, and maturity of blood cells. Hemoglobin of less than 10 g/dl may indicate a carrier, below 7 g/dl is indicative of thalassemia major. In thalassemia major, mean corpuscular volume (MCV) are less than 70 fl, in thalassemia intermedia, MCV levels are below 80 fl (The normal range for MCV is 80–100 fl).[44] The Mentzer index can be a pointer for diagnosis of thalassemia; it can be calculated from a CBC report.[45][44]
- Peripheral blood smear: A blood smear examined under a microscope can show red blood cells that are abnormal in shape (poikilocytosis or codocytes), color (hypochromic), or size (microcytic), as well as those with abnormal inclusions (Heinz bodies).[44]
- Serum iron and ferritin: these tests are needed to rule out iron-deficiency anemia.[44]
For an exact diagnosis, the following tests can be performed:
- Hemoglobin electrophoresis is a test that can detect different types of hemoglobin. Hemoglobin is extracted from the red cells, then introduced into a porous gel and subjected to an electrical field. This separates the normal and abnormal types of hemoglobin which can then be identified and quantified. Due to reduced production of HbA in beta thalassemia, the proportion of HbA2 and HbF relative to HbA are generally increased above normal. In alpha thalassemia the normal proportion is maintained.[46][44][47]
- High-performance liquid chromatography (HPLC) is reliable, fully automated, and able to distinguish most types of abnormal hemoglobin including carriers, The method separates and quantifies hemoglobin fractions by measuring their rate of flow through a column of absorbent material.[48]
- DNA analysis using polymerase chain reaction (PCR) or next-generation sequencing. These tests can identify carriers of thalassemia genes and combination hemoglobinopathies, as well as identifying the exact mutation which underlies the disease.[44][49]
Prevention
Risk factors
Family history and ancestry are factors that increase the risk of beta-thalassemia. Depending on family history, if a person's parents or grandparents had beta thalassemia major or intermedia, there is a 75% (3 out of 4) probability (see inheritance chart at top of page) of the mutated gene being inherited by an offspring. Even if a child does not have symptomatic beta thalassemia they can still be a carrier, leading to an increased risk in future generations of their offspring having beta-thalassemia.[8]
Beta thalassemia occurs most often in people of Mediterranean, Middle Eastern, Southern Asian, and African ancestry.[50]
Counselling and screening
The American College of Obstetricians and Gynecologists recommends all people thinking of becoming pregnant should be offered testing to see if they have thalassemia trait.[51] Genetic counseling and genetic testing are recommended for families who carry a thalassemia trait.[52] Understanding the genetic risk, ideally before a family is started, would hopefully allow families to understand more about the condition and make an informed decision that is best for their family.[52]
A number of countries have programs aimed at reducing the incidence of beta-thalassemia:-
- Cyprus has one of the highest carrier rates in the world. A program of premarital screening and counselling has, since the program's implementation in the 1970s, reduced the number of children born with thalassemia major from one of every 158 births to almost zero.[53][54] Greece also has a screening program to identify people who are carriers.[55]
- In Iran as a premarital screening, the man's red cell indices are checked first. If he has microcytosis (mean cell hemoglobin < 27 pg or mean red cell volume < 80 fl), the woman is tested. When both are microcytic, their hemoglobin A2 concentrations are measured. If both have a concentration above 3.5% (diagnostic of thalassemia trait) they are referred to the local designated health post for genetic counseling.[56]
- Large-scale awareness campaigns are being organized in India both by government and non-government organizations to promote voluntary premarital screening, with marriage between carriers strongly discouraged.[57]
Treatment
Main article: Management of thalassemia
Treatment for thalassemia depends on the severity of the disease. People with thalassemia traits (thalassemia minor or non transfusion dependent thalassemia), may not require medical or follow-up care after the initial diagnosis is made.[58] Occasionally transfusions may be necessary particularly around childbirth, surgery, or if other conditions provoke anemia. A folic acid supplement may also be recommended.[44]
For those with severe forms of thalassemia (thalassemia major, or transfusion-dependent thalassemia), the three principal treatments are red blood cell transfusions to relieve anemia, iron chelation to mitigate the side effects of transfusion, and folic acid supplementation to encourage the growth of new blood cells.[59] Other forms of treatment available depending on individual circumstances.
Red blood cell transfusions
Blood transfusions are the main treatment approach for prolonging life. Donated healthy red blood cells have a functional life of 4 to 6 weeks before they wear out and are broken down in the spleen. Regular transfusions every three to four weeks are necessary in order to maintain hemoglobin at a healthy level. Transfusions come with risks including iron overload, the risk of acquiring infections, and the risk of immune reaction to the donated cells (alloimmunization).[60][61]
Iron chelation
Multiple blood transfusions lead to severe iron overload, as the body eventually breaks down the hemoglobin in donated cells. This releases iron which it is unable to excrete. Iron overload may be treated by chelation therapy with the medications deferoxamine, deferiprone, or deferasirox.[62] Deferoxamine is only effective as a daily injection, complicating its long-term use. Adverse effects include primary skin reactions around the injection site and hearing loss. Deferasirox and deferiprone are both oral medications, whose common side effects include nausea, vomiting and diarrhea.[63]
Folic acid
Folate is a B group vitamin which is involved in the manufacture of red blood cells. Folate supplementation, in the form of folic acid, is often recommended in thalassemia.[60]
Other treatments
Luspatercept
Luspatercept is a drug used to treat anemia in adults with β-thalassemia, it can improve the maturation of red blood cells and reduce the need for frequent blood transfusions. It is administered by injection every three weeks. Luspatercept was authorised for use in the US in 2019 and by the European Medicines Agency in 2020.[64]
Hydroxyurea
Hydroxyurea is another drug that can sometimes be administered to relieve anemia caused by beta-thalassemia. This is achieved, in part, by reactivating fetal haemoglobin production; however its effectiveness is uncertain.[65][66][67]
Osteoporosis
People with thalassemia are at a higher risk of osteoporosis. Treatment options include bisphosphonates and zinc supplementation.[68]
Removal of the spleen

The spleen is the organ which removes damaged or misshapen red blood cells from the circulation. In thalassemia, this can lead to the spleen becoming enlarged, a condition known as splenomegaly. Slight enlargement of the spleen is not a problem, however if it becomes extreme then surgical removal of the spleen (splenectomy) may be recommended.[21]
Transplantation and gene therapy
Hematopoietic stem cells (HSC) are cells in the bone marrow that can develop into all types of blood cells, including red blood cells, white blood cells, and platelets.[69] There are two possible ways to treat hemoglobinopathies by targeting HSCs. One is to transplant HSCs from a healthy donor into the patient's bone marrow; this was pioneered in 1981. More recently, it has become possible to use CRISPR gene editing technology to modify the patient's own HSCs in a way that increases production of functional beta-globin chains, leading to near normal levels of healthy hemoglobin.[70]
All stem cell treatments must involve myeloablation of the patients' bone marrow in order to remove HSCs containing the faulty gene. This requires high doses of chemotherapy agents with side effects such as sickness and tiredness. A long hospital stay is necessary after infusion of the replacement HSCs while the cells take up residence in the bone marrow and start to make red blood cells with the stable form of haemoglobin.[71][72]
Hematopoietic stem cell transplantation
Hematopoietic stem cell transplantation (HSCT) is a potentially curative treatment for both alpha and beta thalassemia. It involves replacing the dysfunctional stem cells in the bone marrow with healthy cells from a well-matched donor. Cells are ideally sourced from human leukocyte antigen matched relatives; the procedure is more likely to succeed in children rather than adults.[73][74]
The first HSC transplant for thalassemia was carried out in 1981 on a patient with beta thalassemia major. Since then, a number of patients have received bone marrow transplants from healthy matched donors, although this procedure has a high level of risk.[75]
In 2018 an unborn child with hydrops fetalis, a potentially fatal complication of alpha thalassemia, was successfully transfused in utero with her mother's stem cells.[76]
HSCT is a dangerous procedure with many possible complications; it is reserved for patients with life-threatening diseases. Risks associated with HSCT can include graft-versus host disease, failure of the graft, and other toxicity related to the transplant.[77] In one study of 31 people, the procedure was successful for 22 whose hemoglobin levels improved to the normal range, in seven the graft failed and they continued to live with thalassemia, and two died of transplantation-related causes.[78]
Gene therapy
Gene therapy for hemoglobinopathies was first trialled in 2014 on a single patient with sickle cell disease (a fault in the beta globin gene),[79] and followed by clinical trials in which a number of patients with either sickle cell or beta thalassemia were successfully treated.[80]
Gene therapies work by first harvesting the patient's HSCs, then using CRISPR gene editing to modify their DNA in the laboratory. In parallel with this, the person with thalassemia disease undergoes a myeloablation procedure (a form of chemotherapy) to destroy the remaining HSCs in their bone marrow. The laboratory treated cells are then infused back into the patient where they colonise the bone marrow and eventually commence production of healthy blood cells. There are fewer risks from this procedure than from HSCT, since the transplanted cells are autologous having originated from the patient herself/himself. [81]
There are two approved forms of gene therapy for beta thalassemia.[82][83]
Betibeglogene autotemcel, sold under the brand name Zynteglo, is a gene therapy for the treatment for beta thalassemia which adds a healthy beta-globin gene to the HSCs.[84] It was approved for medical use in the United States in August 2022.[82][85] The procedure involves collecting hematopoietic stem cells (HSCs) from the affected person's blood. In the laboratory, these HSCs then have a new gene for T87Q-globin (a modified beta-globin) introduced to them using a lentiviral vector. Meanwhile the affected person undergoes myeloablative conditioning, after which the altered HSCs can be infused back, becoming engrafted in the bone marrow where they proliferate. This results in a progressive increase in beta-globin synthesis which improves the balance of alpha and beta globins in all subsequent developing red blood cells. Healthy hemoglobin A is generated resolving the anemia.[81]
Exagamglogene autotemcel, sold under the brand name Casgevy, is a gene therapy for the treatment of transfusion-dependent beta thalassemia which induces increased production of fetal hemoglobin HbF.[86] The treatment was approved in the United Kingdom for the treatment of transfusion-dependent beta thalassemia in November 2023[72] and in the United States in January 2024. Casgevy works by editing the BCL11A gene, which normally inhibits the production of HbF in adults. The edit has the effect of increasing production of gamma globin, a component of fetal hemoglobin HbF, and thereby resolving the anemia.[87]
Combination hemoglobinopathies
A combination hemoglobinopathy occurs when someone inherits two different abnormal hemoglobin genes. If these are different versions of the same gene, one having been inherited from each parent it is an example of compound heterozygosity.[88][89]
Some examples of clinically significant combinations involving beta thalassemia include:
- Hemoglobin C/ beta thalassemia: common in Mediterranean and African populations generally results in a moderate form of anemia with splenomegaly.[90]
- Hemoglobin D/ beta thalassemia: common in the northwestern parts of India and Pakistan (Punjab region).[91]
- Hemoglobin E/ beta thalassemia: common in Cambodia, Thailand, and parts of India, it is clinically similar to β thalassemia major or β thalassemia intermedia.[92]
- Hemoglobin S/ beta thalassemia: common in African and Mediterranean populations, it is clinically similar to sickle-cell anemia.[93]
- Delta-beta thalassemia is a rare form of thalassemia in which there is a reduced production of both the delta and beta globins. It is generally asymptomatic.[94]
Epidemiology
Beta thalassemia is particularly prevalent among the Mediterranean peoples and this geographical association is responsible for its naming: thalassa (θάλασσα) is the Greek word for sea and haima (αἷμα) is the Greek word for blood.[95][96] In Europe, the highest prevalence of beta-thalassemia trait is found in Greece, Turkey, and Mediterranean islands such as Sicily, Sardinia, Corsica, Cyprus, Malta and Crete.[97][98]
Incidence
Beta thalassemia is most prevalent in the "thalassemia belt" which includes areas in Sub-Saharan Africa, and the Mediterranean extending into the Middle East and Southeast Asia.[22] This geographical distribution is thought to be due to the beta-thalassemia carrier state (beta-thalassemia minor) conferring resistance to malaria.[22] In 2005, it was estimated that 1.5% of the world's population are carriers and 60,000 affected infants are born with the thalassemia major annually.[20]
Evolutionary adaptation
The thalassemia trait may confer a degree of protection against malaria, which is historically endemic in the regions where the trait is common.[99] This is thought to confer a selective survival advantage on carriers (known as heterozygous advantage), thus perpetuating the mutation. In that respect, the various thalassemias resemble other genetic disorders affecting hemoglobin, such as sickle-cell disease or Hemoglobin C disease.[100]
See also
References
- ^ a b c d Galanello R, Origa R (May 2010). "Beta-thalassemia". Orphanet Journal of Rare Diseases. 5: 11. doi:10.1186/1750-1172-5-11. PMC 2893117. PMID 20492708.
- ^ Advani P. "Beta Thalassemia Treatment & Management". Medscape. Archived from the original on 4 April 2017. Retrieved 4 April 2017.
- ^ a b "Beta thalassemia". Genetics Home Reference. Archived from the original on 2015-05-13. Retrieved 2015-05-26.
- ^ Fattoum S (10 November 2009). "Evolution of hemoglobinopathy prevention in Africa: results, problems and prospect". Mediterranean Journal of Hematology and Infectious Diseases. pp. e2009005. doi:10.4084/MJHID.2009.005.
- ^ Kattamis A, Forni GL, Aydinok Y, Viprakasit V (December 2020). "Changing patterns in the epidemiology of β-thalassemia". European Journal of Haematology. pp. 692–703. doi:10.1111/ejh.13512.
- ^ McKinney ES, James SR, Murray SS, Nelson K, Ashwill J (2014-04-17). Maternal-Child Nursing. Elsevier Health Sciences. ISBN 978-0-323-29377-8. Archived from the original on 2023-01-14. Retrieved 2020-10-25.
- ^ Lanzkowsky's Manual Of Pediatric Hematology And Oncology 6th Edition ( 2016).
- ^ a b "Beta Thalassemia". Johns Hopkins Medicine. Archived from the original on 2025-01-25. Retrieved 2025-02-18.
- ^ Goldman L, Schafer AI (2015-04-21). Goldman-Cecil Medicine: Expert Consult — Online. Elsevier Health Sciences. ISBN 978-0-323-32285-0.
- ^ a b c Bajwa H, Basit H (2025). "Thalassemia". StatPearls. Treasure Island (FL): StatPearls Publishing. PMID 31424735. Retrieved 2025-02-18.
- ^ Carton J (2012-02-16). Oxford Handbook of Clinical Pathology. OUP Oxford. ISBN 978-0-19-162993-8. Archived from the original on 2023-01-14. Retrieved 2020-10-25.
- ^ Kattamis A, Kwiatkowski JL, Aydinok Y (June 2022). "Thalassaemia". Lancet. 399 (10343): 2310–2324. doi:10.1016/S0140-6736(22)00536-0. PMID 35691301.
- ^ a b Langer AL (8 February 2024). "Beta-Thalassemia". In Adam MP, Feldman J, Mirzaa GM (eds.). GeneReviews®. University of Washington, Seattle. PMID 20301599. Retrieved 2025-02-18.
- ^ "Thalassaemia - Thalassaemia carriers". National Health Service. 17 October 2022. Retrieved 2025-01-27.
- ^ "Alpha Thalassemia". Johns Hopkins Medicine. 27 January 2025. Retrieved 27 January 2025.
- ^ "Clinical commissioning policy: allogeneic haematopoietic stem cell transplantation (Allo-HSCT) for adult transfusion dependent thalassaemia". NHS England. 2023-11-10. Retrieved 2025-01-18.
- ^ "MHRA authorises world-first gene therapy that aims to cure sickle-cell disease and transfusion-dependent β-thalassemia". Medicines and Healthcare products Regulatory Agency (MHRA) (Press release). 16 November 2023. Archived from the original on 25 November 2023. Retrieved 8 December 2023.
- ^ Stuart H. Orkin, David G. Nathan, David Ginsburg, A. Thomas Look (2009). Nathan and Oski's Hematology of Infancy and Childhood, Volume 1. Elsevier Health Sciences. pp. 1054–1055. ISBN 978-1-4160-3430-8.
- ^ Harteveld CL, Higgs DR (May 2010). "Alpha-thalassaemia". Orphanet Journal of Rare Diseases. 5 (1): 13. doi:10.1186/1750-1172-5-13. PMC 2887799. PMID 20507641.
- ^ a b c Rao E, Kumar Chandraker S, Misha Singh M, Kumar R (February 2024). "Global distribution of β-thalassemia mutations: An update". Gene. 896: 148022. doi:10.1016/j.gene.2023.148022. PMID 38007159.
- ^ a b c "Thalassemia-Thalassemia - Symptoms & causes". Mayo Clinic. 17 Nov 2021. Retrieved 2025-01-07.
- ^ a b c d e f g h i j k Taher AT, Musallam KM, Cappellini MD (February 2021). "β-Thalassemias". The New England Journal of Medicine. 384 (8): 727–743. doi:10.1056/NEJMra2021838. PMID 33626255. S2CID 232049825.
- ^ Introduction to Pathology for the Physical Therapist Assistant. Jones & Bartlett Publishers. 2011. ISBN 978-0-7637-9908-3. Archived from the original on 2023-01-14. Retrieved 2020-10-25.
- ^ Angoro B, Motshakeri M, Hemmaway C, Svirskis D, Sharma M (June 2022). "Non-transferrin bound iron". Clinica Chimica Acta; International Journal of Clinical Chemistry. 531: 157–167. doi:10.1016/j.cca.2022.04.004. PMID 35398023.
- ^ "Endocrine Problems in Thalassemia" (PDF). Sandwell and West Birmingham NHS Trust. January 2016.
- ^ "Thalassaemia". Wales Ambulance Service NHS Trust. 25 Oct 2023. Retrieved 8 Jan 2025.
- ^ Saliba AN, Musallam KM, Taher AT (September 2023). "How I treat non-transfusion-dependent β-thalassemia". Blood. 142 (11): 949–960. doi:10.1182/blood.2023020683. PMC 10644094. PMID 37478396.
- ^ Weatherall DJ. The New Genetics and Clinical Practice, Oxford University Press, Oxford 1991.
- ^ a b c d "Hemoglobinopathies". Brigham and Women's Hospital. 17 April 2002. Retrieved 2009-02-06.
- ^ Huisman TH. The structure and function of normal and abnormal haemoglobins. In: Baillière's Clinical Haematology, Higgs DR, Weatherall DJ (Eds), W.B. Saunders, London 1993. p.1.
- ^ Natarajan K, Townes TM, Kutlar A. Disorders of hemoglobin structure: sickle cell anemia and related abnormalities. In: Williams Hematology, 8th ed, Kaushansky K, Lichtman MA, Beutler E, et al. (Eds), McGraw-Hill, 2010. p.ch.48.
- ^ Online Mendelian Inheritance in Man (OMIM): Hemoglobin—Beta Locus; HBB - 141900
- ^ Robbins Basic Pathology, Page No:428
- ^ Thein SL (May 2013). "The molecular basis of β-thalassemia". Cold Spring Harbor Perspectives in Medicine. 3 (5): a011700. doi:10.1101/cshperspect.a011700. PMC 3633182. PMID 23637309.
- ^ Leonard DG (2007-11-25). Molecular Pathology in Clinical Practice. Springer. ISBN 978-0-387-33227-7. Archived from the original on 2023-01-14. Retrieved 2020-10-25.
- ^ Bowen JM, Mazzaferri EL (2012-12-06). Contemporary Internal Medicine: Clinical Case Studies. Springer. ISBN 978-1-4615-6713-4.
- ^ National Organization for Rare Disorders (2003). NORD Guide to Rare Disorders. Lippincott Williams & Wilkins. ISBN 978-0-7817-3063-1. Archived from the original on 2023-01-14. Retrieved 2020-10-25.
- ^ Barton JC, Edwards CQ (2000-01-13). Hemochromatosis: Genetics, Pathophysiology, Diagnosis and Treatment. Cambridge University Press. ISBN 978-0-521-59380-9. Archived from the original on 2023-01-14. Retrieved 2020-10-25.
- ^ Lippincott Williams & Wilkins (2009). Professional Guide to Diseases. Lippincott Williams & Wilkins. ISBN 978-0-7817-7899-2. OCLC 175284310.
- ^ Paulson RF, Hariharan S, Little JA (2020-09-01). "Stress erythropoiesis: definitions and models for its study". Experimental Hematology. 89: 43–54.e2. doi:10.1016/j.exphem.2020.07.011. ISSN 0301-472X. PMC 7508762. PMID 32750404.
- ^ Colah, R. B., Gorakshakar, A. C., & Nadkarni, A. H. (2011). Invasive & non-invasive approaches for prenatal diagnosis of haemoglobinopathies: experiences from India. The Indian Journal of Medical Research, 134(4), 552–560.
- ^ Ghidini A (19 March 2024). "Fetal blood sampling". UpToDate, Inc. Retrieved 2025-01-13.
- ^ "Newborn blood spot test". National Health Service. 5 September 2024. Retrieved 2024-11-20.
- ^ a b c d e f g Bajwa H, Basit H (August 2023). "Thalassemia". StatPearls. Treasure Island (FL): StatPearls Publishing. PMID 31424735. Retrieved 2025-01-13.
- ^ Kottke-Marchant K, Davis B (2012). Laboratory Hematology Practice (1st ed.). John Wiley & Sons. p. 569. ISBN 978-1-4443-9857-1.
- ^ "Hemoglobin Electrophoresis: MedlinePlus Medical Test". medlineplus.gov. Retrieved 2024-11-20.
- ^ Harewood J, Azevedo AM (4 September 2023). "Alpha Thalassemia". StatPearls. Treasure Island (FL): StatPearls Publishing. PMID 28722856. Retrieved 2025-01-13.
- ^ Khera R, Singh T, Khuana N, Gupta N, Dubey AP (March 2015). "HPLC in characterization of hemoglobin profile in thalassemia syndromes and hemoglobinopathies: a clinicohematological correlation". Indian Journal of Hematology & Blood Transfusion. 31 (1): 110–115. doi:10.1007/s12288-014-0409-x. PMC 4275515. PMID 25548455.
- ^ Munkongdee T, Chen P, Winichagoon P, Fucharoen S, Paiboonsukwong K (2020-05-27). "Update in Laboratory Diagnosis of Thalassemia". Frontiers in Molecular Biosciences. 7: 74. doi:10.3389/fmolb.2020.00074. PMC 7326097. PMID 32671092.
- ^ "Risk Factors". Mayo Clinic. Archived from the original on 20 November 2016. Retrieved 4 April 2017.
- ^ "Carrier Screening for Hemoglobinopathies: Sickle Cell Disease and Thalassemia". American College of Obstetricians and Gynecologists. October 2022. Retrieved 21 February 2025.
- ^ a b Hussein N, Henneman L, Kai J, Qureshi N, et al. (Cochrane Cystic Fibrosis and Genetic Disorders Group) (October 2021). "Preconception risk assessment for thalassaemia, sickle cell disease, cystic fibrosis and Tay-Sachs disease". The Cochrane Database of Systematic Reviews. 10 (10): CD010849. doi:10.1002/14651858.CD010849.pub4. PMC 8504980. PMID 34634131.
- ^ Leung TN, Lau TK, Chung TK (April 2005). "Thalassaemia screening in pregnancy". Current Opinion in Obstetrics & Gynecology. 17 (2): 129–134. doi:10.1097/01.gco.0000162180.22984.a3. PMID 15758603. S2CID 41877258.
- ^ Cousens NE, Gaff CL, Metcalfe SA, Delatycki MB (October 2010). "Carrier screening for beta-thalassaemia: a review of international practice". European Journal of Human Genetics. 18 (10): 1077–1083. doi:10.1038/ejhg.2010.90. PMC 2987452. PMID 20571509.
- ^ Loukopoulos D (October 2011). "Haemoglobinopathies in Greece: prevention programme over the past 35 years". The Indian Journal of Medical Research. 134 (4): 572–576. PMC 3237258. PMID 22089622.
- ^ Samavat A, Modell B (November 2004). "Iranian national thalassaemia screening programme". BMJ. 329 (7475): 1134–1137. doi:10.1136/bmj.329.7475.1134. PMC 527686. PMID 15539666.
- ^ Petrou M (January 2010). "Screening for beta thalassaemia". Indian Journal of Human Genetics. 16 (1): 1–5. doi:10.4103/0971-6866.64934. PMC 2927788. PMID 20838484.
- ^ Pediatric Thalassemia~treatment at eMedicine
- ^ "Treatment of Thalassemias". Hematology-Oncology Associates of CNY. 2018-01-25. Retrieved 2025-01-17.
- ^ a b CDC (2025-01-02). "Treatment of Thalassemia". Thalassemia. Retrieved 2025-01-15.
- ^ Butler C (16 January 2025). "Transfusion Issues in Thalassemia" (PDF). The Cooley’s Anemia Foundation. Retrieved 16 January 2025.
- ^ "Thalassaemia - Treatment". nhs.uk. 17 October 2022. Retrieved 2025-01-15.
- ^ Neufeld EJ (2010). "Update on iron chelators in thalassemia". Hematology. American Society of Hematology. Education Program. 2010: 451–455. doi:10.1182/asheducation-2010.1.451. PMID 21239834.
- ^ Cappellini MD, Taher AT (January 2021). "The use of luspatercept for thalassemia in adults". Blood Advances. 5 (1): 326–333. doi:10.1182/bloodadvances.2020002725. PMC 7805339. PMID 33570654.
- ^ Tidy C (23 Feb 2023). "Thalassaemia". Egton Medical Information Systems Limited. Retrieved 2025-01-16.
- ^ Banan M (March 2013). "Hydroxyurea treatment in β-thalassemia patients: to respond or not to respond?". Annals of Hematology. 92 (3): 289–299. doi:10.1007/s00277-012-1671-3. PMID 23318979.
- ^ Ansari SH, Lassi ZS, Khowaja SM, Adil SO, Shamsi TS, et al. (Cochrane Cystic Fibrosis and Genetic Disorders Group) (March 2019). "Hydroxyurea (hydroxycarbamide) for transfusion-dependent β-thalassaemia". The Cochrane Database of Systematic Reviews. 3 (3): CD012064. doi:10.1002/14651858.CD012064.pub2. PMC 6421980. PMID 30882896.
- ^ Bhardwaj A, Swe KM, Sinha NK (May 2023). "Treatment for osteoporosis in people with beta-thalassaemia". The Cochrane Database of Systematic Reviews. 2023 (5): CD010429. doi:10.1002/14651858.CD010429.pub3. PMC 10167785. PMID 37159055.
- ^ "Hematopoiesis". Cleveland Clinic. December 12, 2022. Retrieved 6 December 2024.
- ^ Olson TS, Walters MC (October 2023). "Allogeneic haematopoietic stem-cell transplantation versus gene therapy for haemoglobinopathies". The Lancet. Haematology. 10 (10): e798 – e800. doi:10.1016/S2352-3026(23)00246-6. PMID 37793770.
- ^ "Stem cell transplant - What happens". nhs.uk. 2017-10-23. Retrieved 2024-12-07.
- ^ a b "MHRA authorises world-first gene therapy that aims to cure sickle-cell disease and transfusion-dependent β-thalassemia". Medicines and Healthcare products Regulatory Agency (MHRA) (Press release). 16 November 2023. Archived from the original on 25 November 2023. Retrieved 8 December 2023.
- ^ "NHS England » Clinical commissioning policy: allogeneic haematopoietic stem cell transplantation (Allo-HSCT) for adult transfusion dependent thalassaemia". www.england.nhs.uk. 2023-11-10. Retrieved 2025-01-18.
- ^ Lucarelli G, Isgrò A, Sodani P, Gaziev J (May 2012). "Hematopoietic stem cell transplantation in thalassemia and sickle cell anemia". Cold Spring Harbor Perspectives in Medicine. 2 (5): a011825. doi:10.1101/cshperspect.a011825. PMC 3331690. PMID 22553502.
- ^ Angelucci E, Pilo F, Targhetta C, Pettinau M, Depau C, Cogoni C, et al. (December 2009). "Hematopietic stem cell transplantation in thalassemia and related disorders". Mediterranean Journal of Hematology and Infectious Diseases. 1 (1): e2009015. doi:10.4084/MJHID.2009.015 (inactive 12 July 2025). PMC 3033161. PMID 21415993.
{{cite journal}}: CS1 maint: DOI inactive as of July 2025 (link) - ^ Leigh S (2018-05-25). "Baby Born in World's First In Utero Stem Cell Transplant Trial | UC San Francisco". University of California San Francisco. Retrieved 2025-01-20.
- ^ Rotin LE, Viswabandya A, Kumar R, Patriquin CJ, Kuo KH (December 2023). "A systematic review comparing allogeneic hematopoietic stem cell transplant to gene therapy in sickle cell disease". Hematology. 28 (1): 2163357. doi:10.1080/16078454.2022.2163357. PMID 36728286.
- ^ Sodani P, Isgrò A, Gaziev J, Paciaroni K, Marziali M, Simone MD, et al. (June 2011). "T cell-depleted hla-haploidentical stem cell transplantation in thalassemia young patients". Pediatric Reports. 3 Suppl 2 (Suppl 2): e13. doi:10.4081/pr.2011.s2.e13. PMC 3206538. PMID 22053275.
- ^ Ribeil JA, Hacein-Bey-Abina S, Payen E, Magnani A, Semeraro M, Magrin E, et al. (March 2017). "Gene Therapy in a Patient with Sickle Cell Disease". The New England Journal of Medicine. 376 (9): 848–855. doi:10.1056/NEJMoa1609677. PMID 28249145.
- ^ Kaiser J (5 December 2020). "CRISPR and another genetic strategy fix cell defects in two common blood disorders". ScienceMag.org. Science. Retrieved 7 December 2020.
... teams report that two strategies for directly fixing malfunctioning blood cells have dramatically improved the health of a handful of people with these genetic diseases.
- ^ a b Biffi A (April 2018). "Gene Therapy as a Curative Option for β-Thalassemia". The New England Journal of Medicine. 378 (16): 1551–1552. doi:10.1056/NEJMe1802169. PMID 29669229.
- ^ a b "Zynteglo". U.S. Food and Drug Administration. 17 August 2022. Archived from the original on 26 August 2022. Retrieved 26 August 2022.
- ^ "CRISPR Therapeutics Announces U.S. Food and Drug Administration (FDA) Approval of CASGEVY™ (exagamglogene autotemcel) for the Treatment of Transfusion-Dependent Beta Thalassemia". CRISPR Therapeutics. 14 Jan 2024. Retrieved 20 January 2025.
- ^ Negre O, Eggimann AV, Beuzard Y, Ribeil JA, Bourget P, Borwornpinyo S, et al. (February 2016). "Gene Therapy of the β-Hemoglobinopathies by Lentiviral Transfer of the β(A(T87Q))-Globin Gene". Human Gene Therapy. 27 (2): 148–165. doi:10.1089/hum.2016.007. PMC 4779296. PMID 26886832.
- ^ "FDA Approves First Cell-Based Gene Therapy to Treat Adult and Pediatric Patients with Beta-thalassemia Who Require Regular Blood Transfusions". U.S. Food and Drug Administration (FDA) (Press release). 17 August 2022. Archived from the original on 21 August 2022. Retrieved 20 August 2022.
This article incorporates text from this source, which is in the public domain.
- ^ Stein R (31 October 2023). "FDA advisers see no roadblocks for gene-editing treatment for sickle cell disease". NPR. Archived from the original on 4 December 2023. Retrieved 4 December 2023.
- ^ "Patient Information | CASGEVY® (exagamglogene autotemcel)". www.casgevy.com. Archived from the original on 2024-12-02. Retrieved 2025-01-20.
- ^ Khatri G, Sahito AM, Ansari SA (December 2021). "Shared molecular basis, diagnosis, and co-inheritance of alpha and beta thalassemia". Blood Research. 56 (4): 332–333. doi:10.5045/br.2021.2021128. PMC 8721464. PMID 34776416.
- ^ Wambua S, Mwacharo J, Uyoga S, Macharia A, Williams TN (April 2006). "Co-inheritance of alpha+-thalassaemia and sickle trait results in specific effects on haematological parameters". British Journal of Haematology. 133 (2): 206–209. doi:10.1111/j.1365-2141.2006.06006.x. PMC 4394356. PMID 16611313.
- ^ "Hemoglobin C" (PDF). Washington State Department of Health. February 2011.
- ^ Torres L, Okumura JV, Silva DG, Bonini-Domingos CR (March 2015). "Hemoglobin D-Punjab: origin, distribution and laboratory diagnosis". Revista Brasileira De Hematologia E Hemoterapia. 37 (2): 120–126. doi:10.1016/j.bjhh.2015.02.007. PMC 4382585. PMID 25818823.
- ^ Olivieri NF, Muraca GM, O'Donnell A, Premawardhena A, Fisher C, Weatherall DJ (May 2008). "Studies in haemoglobin E beta-thalassaemia". British Journal of Haematology. 141 (3): 388–397. doi:10.1111/j.1365-2141.2008.07126.x. PMID 18410572.
- ^ Gerber GF (April 2024). "Hemoglobin S–Beta-Thalassemia Disease - Hematology and Oncology". MSD Manual Professional Edition. Retrieved 2024-12-24.
- ^ Pal GK (2005). Textbook Of Practical Physiology (2nd ed.). Orient Blackswan. p. 53. ISBN 9788125029045. Retrieved 17 September 2016.
- ^ Harper D. "thalassemia". Online Etymology Dictionary.
- ^ θάλασσα, αἷμα. Liddell, Henry George; Scott, Robert; A Greek–English Lexicon at the Perseus Project.
- ^ "WHO | Global epidemiology of haemoglobin disorders and derived service indicators". www.who.int. Archived from the original on October 30, 2011. Retrieved 2015-05-26.
- ^ Berg S, Bittner EA (2013-10-16). The MGH Review of Critical Care Medicine. Lippincott Williams & Wilkins. ISBN 978-1-4511-7368-0.
- ^ Abouelmagd A, Ageely HM (2013). Basic Genetics: A Primer Covering Molecular Composition of Genetic Material, Gene Expression and Genetic Engineering, and Mutations and Human Genetic. Universal-Publishers. ISBN 978-1-61233-192-8. Archived from the original on 2023-01-14. Retrieved 2020-10-25.
- ^ Weatherall DJ (2010). "The Thalassemias: Disorders of Globin Synthesis". In Lichtman MA, Kipps TJ, Seligsohn U, Kaushansky K, Prchal JT (eds.). Williams Hematology (8th ed.). The McGraw-Hill Companies. Archived from the original on 2013-11-04. Retrieved 2012-10-02.
Further reading
- Cao A, Galanello R (2010). "Beta-Thalassemia". In Pagon RA, Bird TD, Dolan CR, Stephens K, Adam MP (eds.). GeneReviews. University of Washington, Seattle. PMID 20301599.
- Bahal R, Ali McNeer N, Quijano E, Liu Y, Sulkowski P, Turchick A, et al. (October 2016). "In vivo correction of anaemia in β-thalassemic mice by γPNA-mediated gene editing with nanoparticle delivery". Nature Communications. 7: 13304. Bibcode:2016NatCo...713304B. doi:10.1038/ncomms13304. PMC 5095181. PMID 27782131.
